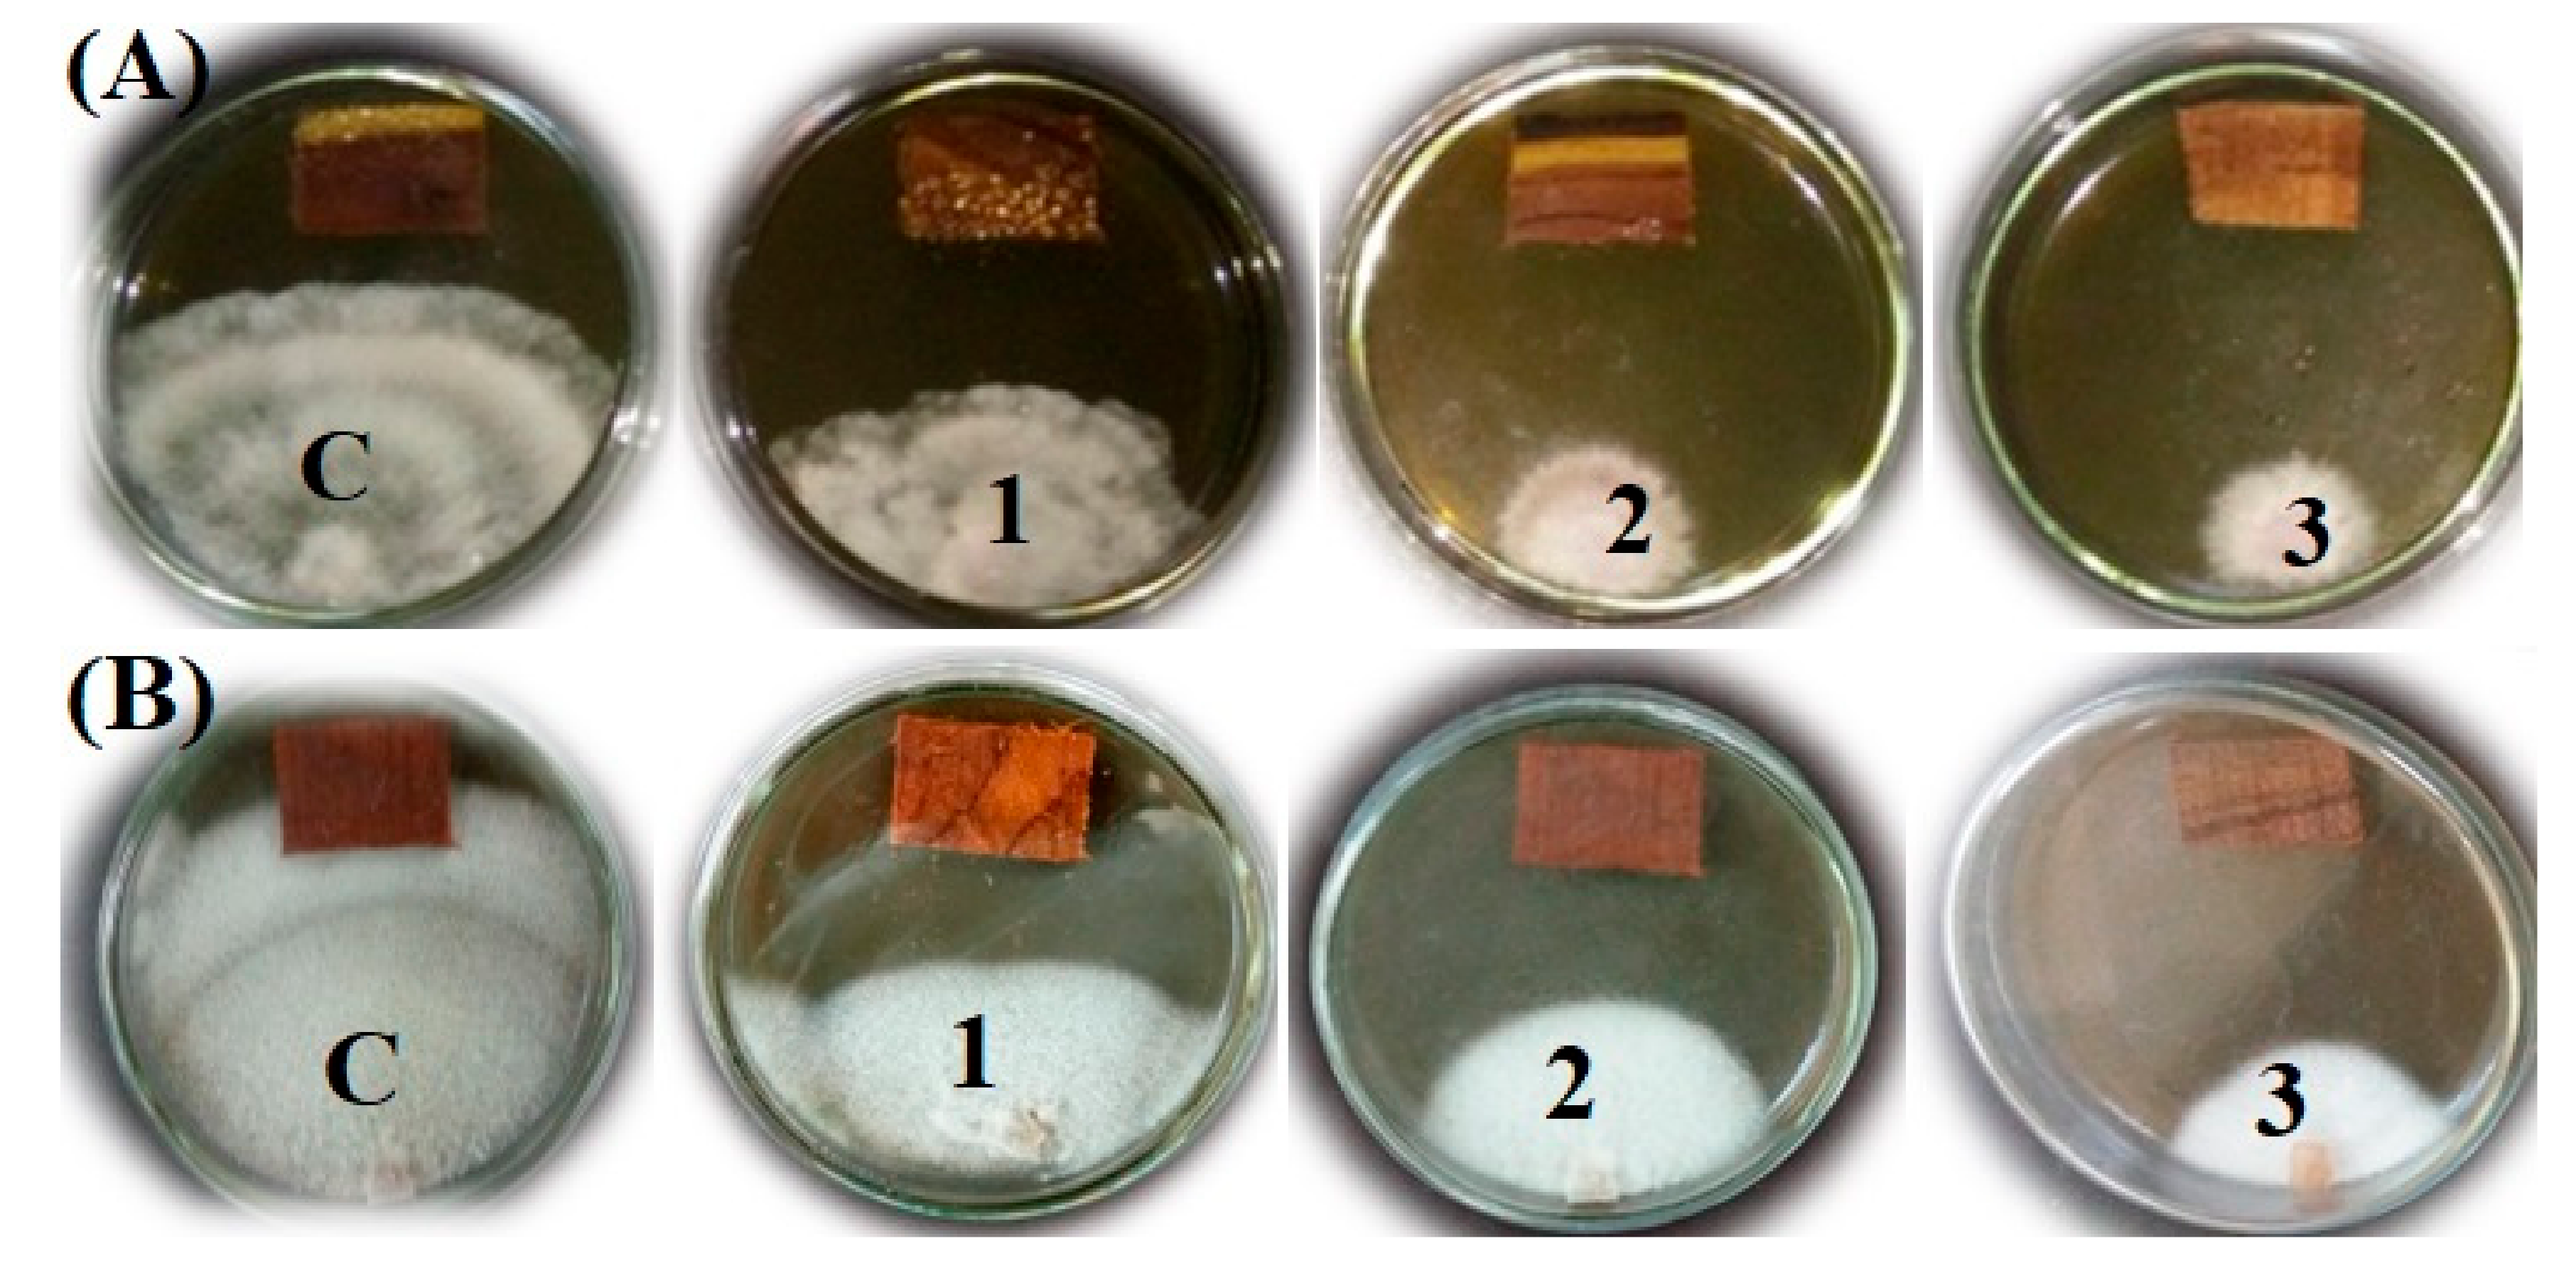

The Potential Antibacterial and Antifungal Activities of Wood Treated with Withania somnifera Fruit Extract, and the Phenolic, Caffeine, and Flavonoid Composition of the Extract According to HPLC
Abstract
1. Introduction
2. Materials and Methods
2.1. Isolation Procedure
2.2. Bacterial Phenotypic Characterization
2.3. DNA Extraction, PCR Analyses, and Sequencing
2.4. Preparation of Wood Blocks
2.5. Extraction and Preparation of Concentrations of Acetone Extract from Withania somnifera fruits
2.6. Treatment of M. azedarach Wood using the Soaking Method
2.7. Antimicrobial Activity of Wood Treated with Acetone Extract
2.8. Analytical HPLC of Phenolic Compounds/Caffeine and Flavonoids for the Acetone Extract
2.9. Statistical Analysis
3. Results
3.1. Bacterial Isolation and Characterization
3.2. In Vitro Visual Observations of the Antibacterial Activity of Extract-Treated Wood
3.3. In Vitro Visual Observations of the Antifungal Activity of Extract-Treated Wood
3.4. Phenolic/Caffeine and Flavonoid Compounds of the Acetone Extract
4. Discussion
5. Conclusions
Author Contributions
Funding
Acknowledgments
Conflicts of Interest
References
- Hintz, T.; Matthews, K.K.; Di, R. The use of plant antimicrobial compounds for food preservation. Biomed. Res. Int. 2015, 2015, 246264. [Google Scholar] [CrossRef]
- Mohanka, R.; Priyanka, D. Plant extract as natural food preservative against spoilage fungi from processed food. Int. J. Curr. Microbiol. Appl. Sci. 2014, 3, 91–98. [Google Scholar]
- Behiry, S.I.; EL-Hefny, M.; Salem, M.Z.M. Toxicity effects of Eriocephalus africanus L. leaf essential oil against some molecularly identified phytopathogenic bacterial strains. Nat. Prod. Res. 2019, 1–5. [Google Scholar] [CrossRef] [PubMed]
- Joerger, R.D. Alternatives to antibiotics: Bacteriocins, antimicrobial peptides and bacteriophages. Poult. Sci. 2003, 82, 640–647. [Google Scholar] [CrossRef]
- Bhattacharya, S.K.; Bhattacharya, D.; Sairam, K.; Ghosal, S. Effect of Withania somnifera glycowithanolides on a rat model of tardive dyskinesia. Phytomedicine 2002, 9, 167. [Google Scholar] [CrossRef]
- Marie Winters, N.D. Ancient medicine, modern use: Withania somnifera and its potential role in integrative oncology. Alter. Med. Rev. 2004, 11, 269–277. [Google Scholar]
- Subramanian, P.; Harikrishnan, B.; Subash, S. Effect of Withania Somnifera root powder on the levels of circulatory lipid peroxidation and liver marker enzymes in chronic hyperammonemia. J. Chem. 2008, 5, 872–877. [Google Scholar] [CrossRef]
- Chatterjee, S.; Srivastava, S.; Khalid, A.; Singh, N.; Sangwan, R.S.; Sidhu, O.P.; Roy, R.; Khetrapal, C.L.; Tuli, R. Comprehensive metabolic fingerprinting of Withania somnifera leaf and root extracts. Phytochemistry 2010, 71, 1085–1094. [Google Scholar] [CrossRef]
- Matsuda, H.; Murakami, T.; Kishi, A.; Yoshikawa, M. Structures of withanosides I, II, III, IV, V, VI, and VII, new withanolide glycosides, from the roots of Indian Withania somnifera Dunel and inhibitory activity for tachyphylaxis to clonidine in isolated guinea-pig ileum. Bioorg. Med. Chem. 2001, 9, 1499–1507. [Google Scholar] [CrossRef]
- Mishra, L.C.; Singh, B.B.; Dagenais, S. Scientific basis for the therapeutic use of Withania somnifera (ashwagandha): A review. Altern. Med. Rev. 2000, 5, 334–346. [Google Scholar]
- Sivanandhana, G.; Aruna, M.; Mayavana, S.; Rajesha, M.; Mariashibub, T.S.; Manickavasagama, M.; Selvarajc, N.; Ganapathi, A. Chitosan enhances withanolides production in adventitious root cultures of Withania somnifera (L.) Dunal. Ind. Crops Prod. 2012, 37, 124–129. [Google Scholar] [CrossRef]
- Rajeev, N.; Parul, J.; Sairta, K.; Alka, P.; Abhishek, G.; Singh, D. Study of Withania somnifera with the spatial reference of phytochemical, FTIR and flavonoids quantification. Int. J. Pharm. Life Sci. 2012, 3, 1530–1532. [Google Scholar]
- Singh, B.; Saxena, A.K.; Chandan, B.K.; Gupta, D.K.; Bhutani, K.K.; Anand, K.K. Adaptogenic activity of a novel, withanolide-free aqueous fraction from the root of Withania somnifera. Phytother. Res. 2001, 15, 311–318. [Google Scholar] [CrossRef] [PubMed]
- Singh, B.; Chandan, B.K.; Gupta, D.K. Adaptogenic activity of a novel withanolide-free aqueous fraction from the roots of Withania somnifera Dun. (Part II). Phytother. Res. 2003, 17, 531–536. [Google Scholar] [CrossRef] [PubMed]
- Singh, G.; Kumar, P. Evaluation of antimicrobial efficacy of flavonoids of Withania somnifera L. Indian J. Pharm. Sci. 2011, 73, 473–478. [Google Scholar] [CrossRef]
- Singh, G.; Kumar, P. Antibacterial potential of alkaloids of Withania somnifera L. & Euphorbia hirta L. Int. J. Pharm. Pharm. Sci. 2012, 4, 78–81. [Google Scholar]
- Deocaris, C.C.; Widodo, N.; Wadhwa, R.; Kaul, S. Merger of ayurveda and tissue culture-based functional genomics: Inspirations from systems biology. J. Transl. Med. 2008, 6, 14. [Google Scholar] [CrossRef]
- Dharajiya, D.; Patel, P.; Patel, M.; Moitra, N. In vitro antimicrobial activity and qualitative phytochemical analysis of Withania somnifera (L.) dunal extracts. Int. J. Pharm. Sci. Rev. Res. 2014, 27, 349–354. [Google Scholar]
- Dhuley, J.N. Therapeutic efficacy of ashwagandha against experimental aspergillosis in mice. Immunopharmacol. Immunotoxicol. 1998, 20, 191–198. [Google Scholar] [CrossRef]
- Owais, M.; Sharad, K.S.; Shehbaz, A.; Saleemuddin, M. Antibacterial efficacy of Withania somnifera (ashwagandha) an indigenous medicinal plant against experimental murine salmonellosis. Phytomedicine 2005, 12, 229–235. [Google Scholar] [CrossRef]
- Romha, G.; Admasu, B.; Gebrekidan, T.H.; Aleme, H.; Gebru, G. Antibacterial activities of five medicinal plants in Ethiopia against some human and animal pathogens. Evid. Based Complement. Altern. Med. 2018, 2018, 2950758. [Google Scholar] [CrossRef] [PubMed]
- Ziauddin, M.; Phansalkar, N.; Patki, P.; Patwardhan, B. Studies on immunomodulatory activity of ashwagandha. J. Ethanopharmocol. 1996, 50, 69–76. [Google Scholar] [CrossRef]
- Salem, M.Z.M.; Behiry, S.I.; Salem, A.Z.M. Effectiveness of root-bark extract from Salvadora persica against the growth of certain molecularly identified pathogenic bacteria. Microb. Pathog. 2018, 117, 320–326. [Google Scholar] [CrossRef] [PubMed]
- Baka, Z.A.M. Antifungal activity of six Saudi medicinal plant extracts against five phytopathogenic fungi. Arch. Phytopathol. Plant Prot. 2010, 43, 736–743. [Google Scholar] [CrossRef]
- Ashmawy, N.A.; Behiry, S.I.; Younes, H.A.; Khaled, A.E. Development of polyclonal rabbit serum-based ELISA for detection of Pectobacterium carotovorum subsp. carotovorum and its specificity against other causing soft rot bacteria. Asian J. Plant Pathol. 2015, 9, 135–141. [Google Scholar] [CrossRef][Green Version]
- Behiry, S.I.; Ashmawy, N.A.; Abdelkhalek, A.A.; Younes, H.A.; Khaled, A.E.; Hafez, E.E. Compatible-and incompatible-type interactions related to defense genes in potato elucidation by Pectobacterium carotovorum. J. Plant Dis. Prot. 2018, 125, 197–204. [Google Scholar] [CrossRef]
- Laurila, J.; Ahola, V.; Lehtinen, A.; Joutsjoki, T.; Hannukkala, A.; Rahkonen, A.; Pirhonen, M. Characterization of Dickeya strains isolated from potato and river water samples in Finland. Eur. J. Plant Pathol. 2008, 122, 213–225. [Google Scholar] [CrossRef]
- Sławiak, M.; Łojkowska, E.; van der Wolf, J.M. First report of bacterial soft rot on potato caused by Dickeya spp. (syn. Erwinia chrysanthemi) in Poland. Plant Pathol. 2009, 58, 794. [Google Scholar] [CrossRef]
- Sławiak, M.; van Beckhoven, J.R.C.M.; Speksnijder, A.G.C.L.; Czajkowski, R.; Grabe, G.; van der Wolf, J.M. Biochemical and genetic analysis reveal a new clade of biovar 3 Dickeya spp. strains isolated from potato in Europe. Eur. J. Plant Pathol. 2009, 125, 245–261. [Google Scholar] [CrossRef]
- Toth, I.K.; van der Wolf, J.M.; Saddler, G.; Lojkowska, E.; Hélias, V.; Pirhonen, M.; Tsror, L.; Elphinstone, J.G. Dickeya species: An emerging problem for potato production in Europe. Plant Pathol. 2011, 60, 385–399. [Google Scholar] [CrossRef]
- Czajkowski, R.; de Boer, W.J.; van der Zouwen, P.S.; Kastelein, P.; Jafra, S.; de Haan, E.G.; van den Bovenkamp, G.W.; van der Wolf, J.M. Virulence of ‘Dickeya solani’ and Dickeya dianthicola biovar-1 and -7 strains on potato (Solanum tuberosum). Plant Pathol. 2012, 62, 597–610. [Google Scholar] [CrossRef]
- Piqué, N.; Miñana-Galbis, D.; Merino, S.; Tomás, J.M. Virulence factors of Erwinia amylovora: A Review. Int. J. Mol. Sci. 2015, 16, 12836–12854. [Google Scholar] [CrossRef] [PubMed]
- Giongo, A.; Ambrosini, A.; Freire, J.; Zanettini, M.; Passaglia, L.M.P. Amplification of 16S rRNA gene sequences to differentiate two highly related bradyrhizobia species. Pesqui. Agropecu. Bras. 2007, 42, 1361–1364. [Google Scholar] [CrossRef][Green Version]
- Sawada, H.; Ieki, H.; Oyaizu, H.; Matsumoto, S. Proposal for Rejection of Agrobacterium tumefaciens and Revised Descriptions for the Genus Agrobacterium and for Agrobacterium radiobacter and Agrobacterium rhizogenes. Int. J. Syst. Bacteriol. 1993, 43, 694–702. [Google Scholar] [CrossRef] [PubMed]
- Mansour, M.M.A.; Salem, M.Z.M.; Khamis, M.H.; Ali, H.M. Natural durability of Citharexylum spinosum and Morus alba woods against three mold fungi. BioResources 2015, 10, 5330–5344. [Google Scholar] [CrossRef][Green Version]
- Sirmah, P.; Dumarçay, S.; Gérardin, P. Unusual amount of (−)-mesquitol from the heartwood of Prosopis juliflora. Nat. Prod. Res. 2009, 23, 183–189. [Google Scholar] [CrossRef]
- Sequeira, S.; Cabrita, E.J.; Macedo, M.F. Antifungals on paper conservation: An overview. Int. Biodeterior. Biodegrad. 2012, 74, 67–86. [Google Scholar] [CrossRef]
- Rosado, T.; Martins, M.R.; Pires, M.; Mirão, J.; Candeias, A.; Caldeira, A.T. Enzymatic monitorization of mural paintings: Biodegradation and biodeterioration. Int. J. Conserv. Sci. 2013, 4, 603–612. [Google Scholar]
- Behiry, S.I.; Okla, M.K.; Alamri, S.A.; EL-Hefny, M.; Salem, M.Z.M.; Alaraidh, I.A.; Ali, H.M.; Al-Ghtani, S.M.; Monroy, J.C.; Salem, A.Z.M. Antifungal and antibacterial activities of Musa paradisiaca L. peel extract: HPLC analysis of phenolic and flavonoid contents. Processes 2019, 7, 215. [Google Scholar]
- Mansour, M.M.A.; Salem, M.Z.M. Evaluation of wood treated with some natural extracts and Paraloid B-72 against the fungus Trichoderma harzianum: Wood elemental composition, In-vitro and application evidence. Int. Biodeterior. Biodegrad. 2015, 100, 62–69. [Google Scholar] [CrossRef]
- Mansour, M.M.A.; Abdel-Megeed, A.; Nasser, R.A.; Salem, M.Z.M. Comparative evaluation of some woody trees methanolic extracts and Paraloid B-72 against phytopathogenic mold fungi Alternaria tenuissima and Fusarium culmorum. BioResources 2015, 10, 2570–2584. [Google Scholar] [CrossRef]
- Salem, M.Z.M.; Zidan, Y.E.; Mansour, M.M.A.; El Hadidi, N.M.N.; Abo Elgat, W.A.A. Antifungal activities of two essential oils used in the treatment of three commercial woods deteriorated by five common mold fungi. Int. Biodeterior. Biodegrad. 2016, 106, 88–96. [Google Scholar] [CrossRef]
- Salem, M.Z.M.; Zidan, Y.E.; Mansour, M.M.A.; El Hadidi, N.M.N.; Abo Elgat, W.A.A. Evaluation of usage three natural extracts applied to three commercial wood species against five common molds. Int. Biodeterior. Biodegrad. 2016, 110, 206–226. [Google Scholar] [CrossRef]
- Salem, M.Z.M.; Mansour, M.M.A.; Elansary, H.O. Evaluation of the effect of inner and outer bark extracts of Sugar Maple (Acer saccharum var. saccharum) in combination with citric acid against the growth of three common molds. J. Wood Chem. Technol. 2019, 39, 136–147. [Google Scholar] [CrossRef]
- Al-Huqail, A.A.; Behiry, S.I.; Salem, M.Z.M.; Ali, H.M.; Siddiqui, M.H.; Salem, A.Z.M. Antifungal, antibacterial, and antioxidant activities of Acacia saligna (Labill.) H. L. Wendl. flower extract: HPLC analysis of phenolic and flavonoid compounds. Molecules 2019, 24, 700. [Google Scholar] [CrossRef]
- Billing, E.; Crosse, J.E.; Garrett, C.M. Laboratory diagnosis of fire blight and bacterial blossom blight of pear. Plant Pathol. 1960, 9, 19–25. [Google Scholar] [CrossRef]
- Schaad, N.W.; Jones, J.B.; Chun, W. (Eds.) Laboratory Guide for Identification of Plant Pathogenic Bacteria, 3rd ed.; APS Press: St Paul, MN, USA, 2001; pp. 40–55. [Google Scholar]
- Ausubel, F.M.; Brent, R.; Kingston, R.E.; Moore, D.D.; Seidman, J.G.; Smith, J.A.; Struhl, K. Preparation of Genomic DNA from Bacteria. In Current Protocols in Molecular Biology; Ausubel, F.M., Brent, R., Kingston, R., Moore, D.D., Seiman, J., Smith, J.A., Struhl, K., Eds.; John Wiley and Sons: New York, NY, USA, 1995. [Google Scholar]
- Salem, M.Z.M.; Ali, H.M.; El-Shanhorey, N.A.; Abdel-Megeed, A. Evaluation of extracts and essential oil from Callistemon viminalis leaves: Antibacterial and antioxidant activities, total phenolic and flavonoid contents. Asian Pac. J. Trop. Med. 2013, 6, 785–791. [Google Scholar] [CrossRef]
- Salem, M.Z.M.; Behiry, S.I.; EL-Hefny, M. Inhibition of Fusarium culmorum, Penicillium chrysogenum and Rhizoctonia solani by n-hexane extracts of three plant species as a wood-treated oil fungicide. J. Appl. Microbiol. 2019, 126, 1683–1699. [Google Scholar] [CrossRef]
- National Committee for Clinical Laboratory Standards. Performance Standards for Antimicrobial Disk Susceptibility Tests Sixth Edition: Approved Standard M2-A6; NCCLS: Villanova, PA, USA, 1997. [Google Scholar]
- Salem, M.Z.M.; Ibrahim, I.H.M.; Ali, H.M.; Helmy, H.M. Assessment of the use of natural extracted dyes and pancreatin enzyme for dyeing of four natural textiles: HPLC analysis of phytochemicals. Processes 2020, 8, 59. [Google Scholar] [CrossRef]
- SAS. Users Guide: Statistics (Release 8.02); SAS Inst Inc.: Cary, NC, USA, 2001. [Google Scholar]
- Ganzera, M.; Chaudhary, M.J.; Khan, I.A. Quantitative HPLC analysis of withanolides in Withania somnifera. Fitoterapia 2003, 74, 68–76. [Google Scholar] [CrossRef]
- Singh, G.; Kumar, P. Antibacterial activity of flavonoids of Withania somnifera L. Int. J. Green Pharm. 2014, 8, 114–118. [Google Scholar] [CrossRef]
- Saidulu, C.; Venkateshwar, C.; Rao, S.G.; Vardhan, T.A. In-vitro antimicrobial Activity of Withania somnifera leaf and root extracts grown in heavy metal toxic soils. Int. J. Adv. Pharm. Biol. Chem. 2014, 3, 872–879. [Google Scholar]
- Khan, Z.S.; Nasreen, S. Phytochemical analysis, antifungal activity and mode of action of methanol extracts from plants against pathogens. J. Agric. Technol. 2010, 6, 793–805. [Google Scholar]
- Nefzi, A.; Ben Abdallah, R.A.; Jabnoun-Khiareddine, H.; Medimagh-Saïdana, S.; Haouala, R.; Daami-Remadi, M. Antifungal activity of aqueous and organic extracts from Withania somnifera L. against Fusarium oxysporum f. sp. radicis-lycopersici. Microb. Biochem. Technol. 2016, 8, 144–150. [Google Scholar] [CrossRef]
- Santhi, M.; Swaminathan, C. Evaluation of antibacterial activity and phytochemeical analysis of leaves of Withania somnifera L. Dunal. Int. J. Curr. Res. 2011, 33, 10–12. [Google Scholar]
- Shafique, S.; Bajwa, R.; Javaid, A.; Shafique, R. Antifungal activity of aqueous extracts of weeds against pathogen of black pointed disease of wheat seeds. Pak. J. Phytopathol. 2006, 18, 174–177. [Google Scholar]
- Javaid, A.; Munir, R. Bioassay guided fractionation of Withania somnifera for the management of Ascochyta rabiei. Int. J. Agric. Biol. 2012, 14, 797–800. [Google Scholar]
- Javaid, A.; Akhtar, R. Antifungal activity of methanolic root extract of Withania somnifera against Fusarium oxysporum f. sp. Cepae. Afr. J. Tradit. Complement. Altern. Med. 2015, 12, 22–27. [Google Scholar] [CrossRef][Green Version]
- Dean, R.; Van Kan, J.A.L.; Pretorius, Z.A.; Hammond-Kosack, K.E.; Di Pietro, A.; Spanu, P.D.; Rudd, J.J.; Dickman, M.; Kahmann, R.; Ellis, J.; et al. The top 10 fungal pathogens in molecular plant pathology. Mol. Plant Pathol. 2012, 13, 414–430. [Google Scholar] [CrossRef]
- Gramaje, D.; Mostert, L.; Groenewald, J.Z.; Crous, P.W. Phaeoacremonium: From esca disease to phaeohyphomycosis. Fungal Biol. 2015, 119, 759–783. [Google Scholar] [CrossRef]
- Wood, A.R.; Morris, M.J. Impact of the gall-forming rust fungus Uromycladium tepperianum on the invasive tree Acacia saligna in South Africa: 15 years of monitoring. Biol. Control 2007, 41, 68–77. [Google Scholar] [CrossRef]
- Gomes, R.R.; Glienke, C.; Videira, C.I.R.; Lombard, L.; Groenewald, J.Z.; Crous, P.W. Diaporthe: A genus of endophytic, saprobic and plant pathogenic fungi. Persoonia 2013, 31, 1. [Google Scholar] [CrossRef]
- Li, G.Q.; Liu, F.F.; Li, J.Q.; Liu, Q.L.; Chen, S.F. Botryosphaeriaceae from Eucalyptus plantations and adjacent plants in China. Persoonia 2018, 40, 63–95. [Google Scholar] [CrossRef]

| HPLC Conditions | Phenolic/Caffeine Compounds | Flavonoid Compounds |
|---|---|---|
| Instrument | Agilent 1260 Infinity HPLC Series equipped with a Quaternary pump and a Zorbax Eclipse plus C18 column (100 mm × 4.6 mm i.d.) (Agilent, Santa Clara, CA, USA) | Smart line (Knauer, Germany) equipped with a binary pump and a Zorbax Eclipse plus C18 (column 150 mm × 4.6 mm i.d.) (Agilent technologies, Santa Clara, CA, USA) |
| Temperature of operation | 30 °C | 35 °C |
| Separation elution gradient | A: HPLC grade water 0.2% H3PO4 (v/v) B: Methanol C: Acetonitrile | Methanol: H2O with 0.5% H3PO4 (50:50) Flow rate 0.7 mL/min |
| Injected volume | 20 μL | 20 μL |
| Detector | Variable wavelength detector (VWD) at 284 nm | UV detector at 273 nm |
| Characteristic | Bacterial Isolate | ||||
|---|---|---|---|---|---|
| Erwinia amylovora | Agrobacterium tumefaciens | Pseudomonas cichorii | Dickeya solani | Serratia plymuthica | |
| GenBank accession number of 16S rDNA sequence | MK720288 | MK720285 | MK720283 | MK720279 | MK720275 |
| Shape (rods) | - | - | - | - | - |
| Gram staining | + | + | + | + | + |
| Motility | + | + | + | + | + |
| Anaerobic growth | + | + | + | + | + |
| 3-Ketolactose production | + | - | + | + | + |
| Growth at 37 °C | - | - | + | + | + |
| Catalase test | + | + | - | + | + |
| Mucoid growth | + | + | - | + | + |
| Oxidase reaction | - | + | + | - | - |
| Pigment on kingsB | nd | nd | + | + | + |
| Indole production | - | - | - | + | - |
| R. substance from sucrose | - | - | - | - | - |
| Urease production | - | - | - | - | - |
| Growth in 5% NaCl | - | - | + | - | + |
| Citrate utilization | - | + | - | + | - |
| Malonate utilization | - | - | + | + | - |
| Alkali from tartaric acid | nd | + | + | + | - |
| Glucose | a | - | - | + | + |
| α-methyl glucoside | - | - | a | a | a |
| Maltose | - | - | - | - | a |
| Sucrose | a | a | a | a | a |
| Lactose | a | a | - | a | a |
| Dulcitol | a | a | - | a | a |
| Manitol | a | a | a | a | a |
| Trehalose | a | a | - | a | a |
| Conc. | Inhibition Zone (mm ± SD) | ||||
|---|---|---|---|---|---|
| Agrobacterium tumefaciens | Dickeya solani | Erwinia amylovora | Pseudomonas cichorii | Serratia pylumthica | |
| Control (10% DMSO) | 0.00 c * | 0.00 b | 0.00 c | 0.00 c | 0.00 c |
| 1% | 60.33 b ± 3.05 | 31.66 a ± 1.15 | 61.33 b ± 1.15 | 79 b ± 1.73 | 0.00 c |
| 2% | >90 a | 31.66 a ± 0.57 | >90 a | >90 a | 76 b ± 1.73 |
| 3% | >90 a | 31.66 a ± 0.57 | >90 a | >90 a | >90 a |
| LSD0.05 | 2.87 | 1.33 | 1.08 | 1.63 | 1.63 |
| Conc. | Inhibition Percentage (%) | |
|---|---|---|
| Fusarium culmorum | Rhizoctonia solani | |
| Control (10% DMSO) | 0.00 d * | 0.00 d |
| 1% | 49.62 c | 49.25 c |
| 2% | 65.92 b | 53.33 b |
| 3% | 84.07 a | 67.03 a |
| LSD0.05 | 1.81 | 1.35 |
| Compound | Conc. (mg/100 g extract) |
|---|---|
| Phenolic/caffeine compounds | |
| Gallic acid | 0.58 |
| Catechol | ND * |
| p-Hydroxy benzoic acid | ND |
| Caffeine | 0.31 |
| Vanillic acid | 4.78 |
| Caffeic acid | 0.75 |
| Syringic acid | ND |
| Vanillin | 0.82 |
| p-Coumaric acid | 0.34 |
| Ferulic acid | 0.54 |
| Ellagic acid | 0.93 |
| Benzoic acid | ND |
| o-Coumaric acid (trans-2-Hydroxycinnamic acid) | 1.22 |
| Salicylic acid | 9.49 |
| Cinnamic acid | ND |
| Flavonoid compounds | |
| Rutin | 4702.58 |
| Myricetin | 1386.62 |
| Quercetin | ND |
| Naringenin | ND |
| Kaempferol | 8.29 |
| Apigenin | ND |
© 2020 by the authors. Licensee MDPI, Basel, Switzerland. This article is an open access article distributed under the terms and conditions of the Creative Commons Attribution (CC BY) license (http://creativecommons.org/licenses/by/4.0/).
Share and Cite
EL-Hefny, M.; Salem, M.Z.M.; Behiry, S.I.; Ali, H.M. The Potential Antibacterial and Antifungal Activities of Wood Treated with Withania somnifera Fruit Extract, and the Phenolic, Caffeine, and Flavonoid Composition of the Extract According to HPLC. Processes 2020, 8, 113. https://doi.org/10.3390/pr8010113
EL-Hefny M, Salem MZM, Behiry SI, Ali HM. The Potential Antibacterial and Antifungal Activities of Wood Treated with Withania somnifera Fruit Extract, and the Phenolic, Caffeine, and Flavonoid Composition of the Extract According to HPLC. Processes. 2020; 8(1):113. https://doi.org/10.3390/pr8010113
Chicago/Turabian StyleEL-Hefny, Mervat, Mohamed Z. M. Salem, Said I. Behiry, and Hayssam M. Ali. 2020. "The Potential Antibacterial and Antifungal Activities of Wood Treated with Withania somnifera Fruit Extract, and the Phenolic, Caffeine, and Flavonoid Composition of the Extract According to HPLC" Processes 8, no. 1: 113. https://doi.org/10.3390/pr8010113
APA StyleEL-Hefny, M., Salem, M. Z. M., Behiry, S. I., & Ali, H. M. (2020). The Potential Antibacterial and Antifungal Activities of Wood Treated with Withania somnifera Fruit Extract, and the Phenolic, Caffeine, and Flavonoid Composition of the Extract According to HPLC. Processes, 8(1), 113. https://doi.org/10.3390/pr8010113

